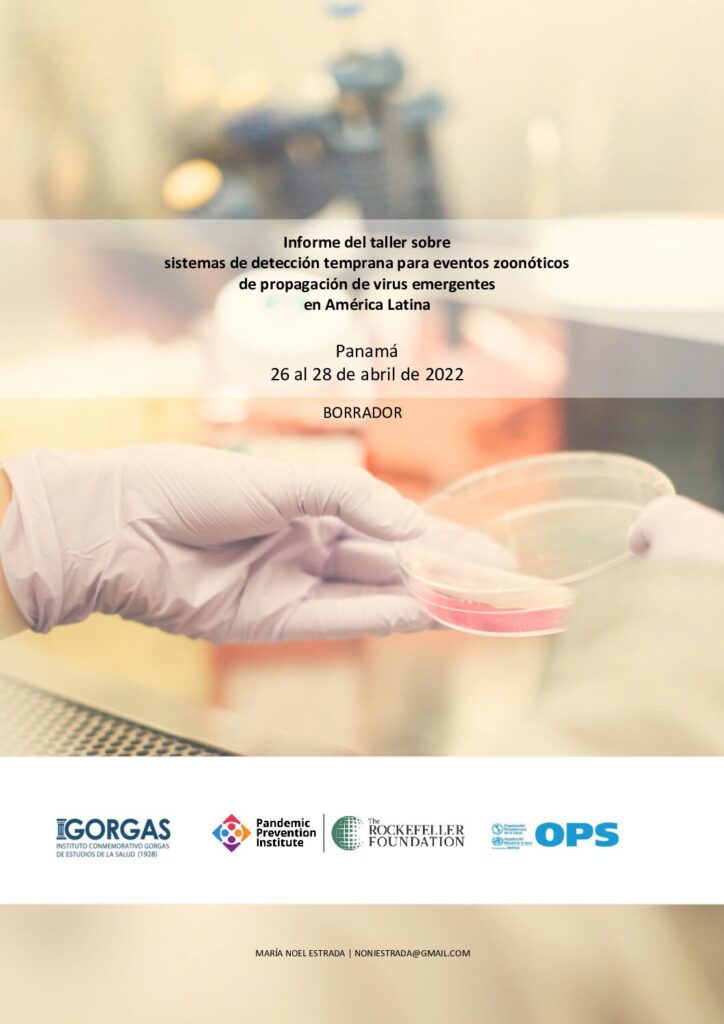

Our Program History
The GHSS team has a relentless commitment to advancing health and health security programs, driven by a vision to protect lives, strengthen communities, and bolster global resilience against health threats. Our team members have a long track record of orchestrating and leading high-impact programs on both national and international stages, spearheading initiatives ranging from outbreak preparedness and response, innovative health finance, translational technology innovation, to bioterrorism preparedness and disaster response globally.
We are proud of our influential, trusted global relationships across India, East & West Africa, and the Americas, with key figures in Ministries, national-level scientific organizations, non-governmental groups, and foundations. This extensive network has become a driving force behind the success of GHSS mission-aligned objectives.
We are motivated by the potential of making a lasting impact on the health and well-being of individuals and communities globally. Please feel welcome to connect with the GHSS team if you are looking to collaborate and partner to make a lasting impact on Global Health Security.
Global Reach and Impact
Disease Surveillance and Preparedness & Response
Health Innovations
National Security
Networks and Alliances
One Health Thought Leadership

- Formed inter-sectoral / ministerial partnership to launch the India One Health Anthrax surveillance program.
- Collaborated with the Gorgas Memorial Institute to implement a pan-regional surveillance strategy for Emerging Infectious Diseases (EIDs).
- In partnership with the Institute Pasteur, Dakar, launched a multi country (Senegal, Mali, Burkina Faso) genomics surveillance program for Viral Hemorrhagic Fevers.

- In partnership with FIOCRUZ/CIDACS pioneered and co-developed Brazil’s state of the art infectious disease outbreak early warning system (AESOP).
- Co-led the launch of global health innovation alliances such as the Climate Health Innovation Fund and the U.S./India Joint Center for Biosensing Innovation.
- Spearheaded / supported the development of the next gen Sample to Sequencer (S2S) metagenomic sequencing system, along with several diagnostic innovations.

- Spearheaded the U.S. deployment and operation of mobile diagnostic laboratories in response to the Ebola outbreak in Sierra Leone and Guinea (2014-16).
- Led a diversity of counter weapons of mass destruction (CWMD) programs with a particular focus on biological threats.
- Implemented Biological Threat Reduction Programs (BTRP) across former Soviet Union countries, Africa and Asia.

- In support of the WHO-EMRO, launched a pan regional program towards the development of a Middle East / N. Africa genomic surveillance network.
- Established strategic partnerships with the Pasteur Network focused on global infectious disease discovery, surveillance & response, as well as health innovations.
- Launched global Alliance for Preparedness and Response (APAR) based on the New Delhi One Health Conference declaration, gaining endorsement from representatives of 28 countries, and key global stakeholder organizations.

- Orchestrated the 2019 New Delhi One Health India conference in partnership with Government of India Ministries and global stakeholders, resulting in the launch of India’s intersectoral One Health Program.
- Collaborated with the Pan American Health Organization to vision a Latin America wide Emerging and Re-Emerging Infectious Disease surveillance program.
- In partnership with Sri Balaji Vidyapeeth University, WHO, FAO and OIE hosted a series of global convenings addressing global challenges to One Health Security at the intersect of human, animal, and environmental health.
Program Priorities & Strategy

How We Make an Impact – Convergence Partnerships
Thrust – 1
Discovery & Forecasting of Global (re) – Emerging Pathogenic Threats
Thrust – 2
CC & Anthropogenic EID Drivers & PPR Systems Approaches
Thrust – 3
Advance Medical Countermeasures
Thrust – 4
Over the Horizon – Threat Assessment & Response

Digital Surveillance & Forecasting

Systems Solutions To PPR

Rapid Threat Discovery

Therapeutics & Vaccines

Novel Diagnostics

Threat Assessments & Response
Interdisciplinary Innovation Pillars
Bio/Med & Social Sciences
Engineering & Material Science
Climate Change Research
Field & Lab Test Beds
Demand Driven
Innovation Teams
Global Partner Networks
Industry
Partners & Stake-holders
Enabling Infrastructure (Labs, Computing, Other)
Disease Dynamic Mling
Other
Stakeholder Engagement for Sustainable Health Programs
At GHSS, we prioritize the engagement of local, global, and regional stakeholders to ensure that every program we design, and implement is not only fit for purpose but also deeply rooted in the communities it serves. By integrating the voices and expertise of affected populations and local partners, we create solutions that are more relevant, culturally appropriate, and sustainable in the long term. GHSS’ CEO, Kay van der Horst, brings decades of experience in successfully collaborating with diverse stakeholders to co-create health security programs that address emerging health threats, while fostering resilience in some of the most vulnerable regions around the world. This commitment to stakeholder-driven development ensures that our programs are adaptable, community-centered, and impactful across various global settings.
1) Asian Development Bank (ADB):
The Global Technical Assistance Platform for Climate and Health (GTAP)
2) Pasteur Network:
Adapting Early Warning to a Changing Environment
3) WHO – EMRO:
Technical Workshop to Establish Genomic Surveillance Network in the Eastern Mediterranean Region for Emerging & Re-Emerging Infectious Diseases
4) Pan American Health Organization (PAHO):
Expert Convening on Early Detection Systems for Zoonotic Spillover Events of Emerging and Re-Emerging Viruses in Latin America
5) FIOCRUZ, Brazil:
Strategic Co-Creation Workshop for the Alert Early System of Outbreaks with Pandemic Potential
6) Government of India:
Visioning, Planning and Launch of India’s One Health Program
1 ) Asian Development Bank (ADB): The Global Technical Assistance Platform for Climate and Health (GTAP)
The Asian Development Bank (ADB) recently engaged Kay van der Horst as a senior expert consultant on Climate and Health to spearhead a global stakeholder engagement process aimed at evaluating the desirability and viability of the groundbreaking Global Climate and Health Technical Assistance Platform (GTAP)
GTAP is a transformative initiative designed to serve as a dynamic platform of knowledge and expertise at the intersection of climate and health. It integrates quality-assured data, advanced analytical tools, and collaborative strategies to inform and guide effective climate mitigation and adaptation interventions across pan-regional, regional, and national levels. The platform is intended to be a vital resource for institutions and organizations working to address the complex and evolving challenges posed by climate change and its impact on health systems.


To ensure that GTAP is tailored to meet the diverse needs of its stakeholders, Kay van der Horst led a comprehensive stakeholder engagement process. This involved in-depth consultations with representatives from multilateral development banks, academia, civil analysis, he developed a sustainable roadmap for the creation and implementation of the platform.
GTAP’s initial focus will be on the Asia-Pacific region, with its official launch planned for early 2025. Over time, it is envisioned to expand and evolve into a global resource, serving as a common good to drive climate-resilient health interventions worldwide.
While serving as Managing Director of Global Health Programs at the Rockefeller Foundation, Kay van der Horst emphasized the importance of stakeholder-informed project design and implementation. In addition to providing resources, he offered thought leadership by actively engaging diverse intersectoral and interdisciplinary stakeholders. This approach ensured that program priorities, design, and sustainability were informed by the broadest possible range of insights, fostering deeper collaboration and co-creation. Notable examples of these efforts include:
2) Adapting Early Warning Systems to a Changing Environment in the Pasteur Network
Building on a longstanding professional relationship with Institut Pasteur, Kay van der Horst forged a strategic partnership between the Rockefeller Foundation and the Pasteur Network. To shape this collaboration, a three-day convening, titled Climate-Sensitive Disease: Adapting Early Warning to a Changing Environment in the Pasteur Network, was held in Paris from June 13 to June 15, 2023. This convening brought together a diverse group of stakeholders, including representatives from most of the Pasteur Network’s institutes, to discuss and develop future projects aimed at integrating climate-sensitive approaches into local, regional, and global health initiatives.


The main goal of the convening was to inform the development of a phased strategy for the Pasteur Network, leveraging novel disease prediction and forecasting tools alongside modern disease surveillance systems. This integrated approach aims to address the link between climate change and the emergence and re-emergence of infectious diseases, with a strong focus on enhancing public health decision-making.
3) WHO – EMRO: Technical Workshop to Establish Genomic Surveillance Network in the Eastern Mediterranean Region for Emerging & Re-Emerging Infectious Diseases
With a vision towards building post pandemic surveillance capacities, under van der Horst’s leadership, the Rockefeller Foundation resources the WHO Eastern Mediterranean Regional Office (WHO/EMRO) Infectious Hazard Preparedness Laboratory team to organize a technical workshop to seek regional input into a strategy for establishing a genomic surveillance network for emerging and re-emerging pathogens in the Eastern Mediterranean region (Amman, Jordan, Feb. 01-02, 2023).


The meeting brought together a broad range of stakeholders from national, regional and international platforms, including institute directors from human and veterinary health departments, laboratory, surveillance and epidemiology experts, policy makers, donors and representatives from regional and UN entities including the Food and Agriculture Office (FAO) and World Organization for Animal Health
(WOAH). The objective of the meeting was to consult with these expert stakeholders on the scope, terms of reference, objectives and implementation of the genomics surveillance strategy, and identify the critical areas of support that the network should address. Multi-level and cross-sectoral discussion was encouraged, to ensure a broad range of inputs could be consolidated into the strategy, aiming to ensure tangible interventions and support that would work at all levels of the network to support expansion and sustainability of genomic surveillance establishing during the COVID-19 pandemic and as part of the Global Influenza Surveillance Service (GISRS).

4) Pan American Health Organization (PAHO): Expert Convening on Early Detection Systems for Zoonotic Spillover Events of Emerging and Re-Emerging Viruses in Latin America
Building on a long-standing collaboration with the Pan American Health Organization (PAHO) to develop and implement COVID-19 genomic surveillance networks, co-funded by the Rockefeller Foundation, and efforts to establish pan-regional surveillance systems for emerging and re-emerging infectious diseases with the Gorgas Memorial Institute (Instituto Conmemorativo Gorgas de Estudios de la Salud), Kay van der Horst partnered with these institutions to host a pan-regional expert convening on the threats posed by emerging infectious diseases in the Americas (Dates: 26 – 28th of April, 2022). The event was designed as a hybrid format, with virtual and in-person sessions during the mornings, followed by in-person working groups on the first and second afternoons.

The convening aimed to assess existing capacities in Latin America for the early detection and surveillance of spillover events across both the animal and public health sectors and to outline coordinated strategies for developing a regional surveillance system. Specific objectives included:
- Conducting a landscape analysis of laboratory needs and existing capacities to detect emerging pathogens in Latin America.
- Reviewing experiences in the surveillance of emerging viruses in wildlife, farm animals, and humans that could aid in the early identification and alert of potential spillover events.
- Providing an overview of funding initiatives and plans by international donors focused on enhancing regional surveillance in Latin America.
- Identifying key next steps toward the development of an integrated regional surveillance system.
Participants included professionals from select countries (Argentina, Brazil, Colombia, Mexico, Panama, and Peru) responsible for national surveillance and laboratory services for emerging pathogens across public, animal health, and wildlife sectors; experts from academia and research projects; representatives from donor agencies and foundations; and personnel from the organizing entities (Instituto Gorgas, Rockefeller Foundation, PAHO).

Key findings and priority actions identified during the convening included:
- Strengthening sustainable intersectoral collaboration and coordination at the human-animal interface.
- Expanding and reinforcing national laboratory capacities, regional networks, and collaborative efforts within the network.
- Developing a proposal for a regional framework for surveillance, early detection, and data sharing on emerging pathogens that can be adapted to national early detection systems.
- Linking surveillance and early detection to response mechanisms, particularly containment at the source, by establishing and strengthening rapid response capacities with the specific expertise needed to address emerging pathogens.
5) FIOCRUZ, Brazil: Strategic Co-Creation Workshop for the Alert Early System of Outbreaks with Pandemic Potential

In early 2022, Kay van der Horst established a partnership with Brazil’s Oswaldo Cruz Foundation (FIOCRUZ) to create the pioneering Alert Early System of Outbreaks with Pandemic Potential (AESOP). This system is designed to enhance Brazil’s epidemic prevention capabilities and serve as a model that can be adopted by global partners for broader pandemic prevention efforts.
To shape the vision for AESOP, a strategic co-creation workshop was hosted by FIOCRUZ from June 7th to 9th, 2022. This key event brought together a diverse group of interdisciplinary stakeholders from the health, veterinary, and environmental sectors. The goal was to collaboratively design a comprehensive, robust system and develop a vision framework that would be relevant and fit for purpose for a wide range of end users, including policymakers, ministries, local and regional decision-makers, and the scientific community. While AESOP initially focused on predicting outbreaks of respiratory illnesses and arboviruses, future capabilities to detect other emerging pathogens, such as arenaviruses, were also envisioned.

The workshop was attended in person by 36 professionals from various fields, including academia, the innovation sector, and government bodies dedicated to epidemiological surveillance. An additional four participants joined remotely, resulting in a total of 40 participants from five different countries.

Stakeholder feedback and insights were gathered through sub-group working sessions that addressed various aspects of system design, data sharing, modeling, and use case scenarios. These sessions were documented by session leads, while a graphic designer developed a visual storyboard that effectively captured the key discussions and ideas. These murals can be viewed in the detailed meeting report linked below.
Today, AESOP is fully operational in Brazil and is being expanded across the Amazon basin regions. Progress and updates on the system can be followed at Http://aesop.health
6) Government of India: Visioning, Planning and Launch of India’s One Health Program
While leading Penn State’s Applied Biological and Biosecurity Research Laboratory (ABRL), van der Horst’s team, with support from the Bill and Melinda Gates Foundation and the United States Defense Threat Reduction Agency’s Biological Threat Reduction Program, established a strong partnership with India’s Department of Biotechnology (DBT) under the Ministry of Science and Technology to help launch India’s ambitious One Health Initiative.
Throughout 2017 and 2018, van der Horst worked closely with DBT leadership and the Institute for Animal Health and Veterinary Biologicals (IAHVB) to coordinate and facilitate a series of scientific planning workshops.
These workshops brought together senior representatives and thought leaders from key Indian government ministries, including the Indian Council of Medical Research (ICMR), the National Center for Disease Control (NCDC), the Indian Council of Agricultural Research (ICAR), and the Defense Research and Development Organization (DRDO).
State agencies and a diverse range of intersectoral stakeholders also participated, laying the groundwork for the successful launch of this critical initiative. The One Health Initiative embodies an integrated, intersectoral approach to addressing urgent health threats across India, focusing on both human and animal health while considering environmental factors. These foundational efforts culminated in the One Health India Conference, held on February 18-19, 2019, in New Delhi.

The conference was inaugurated by Dr. Harsh Vardhan, India’s Minister of Science and Technology, who emphasized the need for a “collaborative, multisectoral, and trans-disciplinary approach for designing and implementing programs, policies, and legislation, supported by basic and applied research.” He underscored the importance of the One Health approach in protecting global health and securing livelihoods by addressing both human and animal health concerns in an integrated manner.

The conference was inaugurated by Dr. Harsh Vardhan, India’s Minister of Science and Technology, who emphasized the need for a “collaborative, multisectoral, and trans-disciplinary approach for designing and implementing programs, policies, and legislation, supported by basic and applied research.” He underscored the importance of the One Health approach in protecting global health and securing livelihoods by addressing both human and animal health concerns in an integrated manner.
The conference brought together over 250 participants from 21 countries, including experts and leaders in fields such as brucellosis, anthrax, tuberculosis, antimicrobial resistance, biosafety, and disease burden, as well as key figures in intersectoral collaboration.

Discussions focused on potential solutions for risk mitigation and control, fostering interdisciplinary dialogue on ways to coordinate efforts and address major health challenges at the regional, national, and global levels.
The event concluded with an Inter-Ministerial Declaration, which set forth a framework for India on future preparedness, response, and management of current and emerging health challenges using a One Health collaborative approach. The conference also initiated international collaborations, providing a platform for researchers, medical and veterinary practitioners, public and private sector stakeholders, and policymakers to integrate knowledge, identify needs, and explore opportunities for more effective coordination across human, animal, and environmental health sectors.